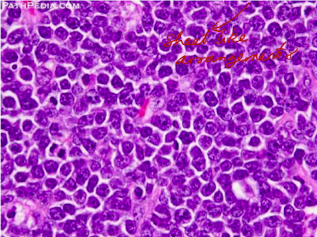

What is a neoplasm?
Refers the persistence of tumors, even after the inciting stimulus is gone, results from genetic alterations that are passed down to the progeny of the tumor cells. These genetic changes allow excessive and unregulated proliferation that becomes autonomous (independent of physiologic growth stimuli)
Name the components of the neoplasm that is shown below:

Red = the neoplastic cells themselves no longer responding to cellular signalling mechanisms
Light blue arrows = neoplastic stroma supporting the neoplasm structurally
Orange = the immune cells themselves
Green = red blood vessel formation
Name the type of neoplastic cell that is shown below and provide an example of a neoplasm that may have caused this:
Round cells - all immune cells do this
Name the type of neoplastic cell that is shown below and provide an example of a cell that might do this:

Mesenchymal cells: spindle cells (cells like fibroblasts and myocytes)
Name the type of neoplastic cell that is shown below and provide an example of a type of cell that would do this:

Epithelial cells: skin and epithelial cells, glandular cells - these can look squamous, polygymal, pumps, lumps, islands and trabeculae
What types of cells are generally more prone to becoming neoplastic?
- Permanent cardiac myocytes are much less likely to become neoplastic
- Labile and stable cells are more susceptible - permanent cells are not really dividing as much by comparison
Can some non-neoplastic changes develop into neoplasia?
Yes
What are some methods beyond histology that can be used to assess whether a tissue is neoplastic?
- Radiology
- Use PCR - polyclonal is less likely to be a neoplasm, whereas monoclonal is more likely to be a neoplasm
How do round cells differ from epithelial cells on cytology?
Round cells: these can look like epithelial cells (one key difference is that they do not clump together they will be individualised
Epithelial cells: they hold onto each other unlike round cells - epithelial cells like to form together to form clusters or bands
How do mesenchymal cells appear histologically?
They typically appear as being spindle shaped with long wispy projections
Name the origins of the neoplasms in the image below:

- Lymphocytes
- Mast cells
- Melanocytes
- Plasma cells
- Macrophages
Name the origin of the mesenchymal cells below:

- Fibroblasts as they are producing collagen
- Producing bone and hence a tumour of bone
- Neoplasm of cartiladge
- Blood vessels - probably a neoplasm of enodthelial cells
- Looks like fat - benign tumour of adipocytes or lipocytes (lipoma)
- Less well differentiated neoplasm of fat cells (liposarcoma)
Name the neoplasms that are shown in the image below:

- Hepatocytes
- Gastric mucosal epithelial cells or mucosal epithelium or any part of alimentry tract
- Epidermal Keratinocytes
- Renal tubular epithelial cells
- Mammary glandular epithelium
Contrast the two terms benign and malignant:
Benign: no invasion, well demarcated, no metastasis, low mitotic rate, often smaller, ulcers + necrosis & haemmorage is rare, diseases are due to space occuping lesions or tumour products, resemble the tissue of origin, mild anisocytosis and anisokaryosis, minimal nuclear atypia
Malignant: locally invase, poorly demarcated, metastasis common, rapid growth rate and high mitotic rate, often larger, often ulcerate & contains necrosis and haemmorrhage, disease due to metastasis, poorly differentiated (loss of resemblance), marked anisocytosis (variation in cell size) and anisokaryosis (variation in nuclear size), nuclear atypia (abnormal shapes and multiple nuclei)
How are epithelial neoplasms named?
Benign - end is -oma or papilloma if papillary
Malignant - called a carcinoma or an adenocarcinoma (glandular)
How are neoplasms of mesenchymal cells named?
Benign - ends in -oma
Malignent - end in -sarcoma
How are round neoplasms nomenclaturised?
No consistent nomenclature exists for them


